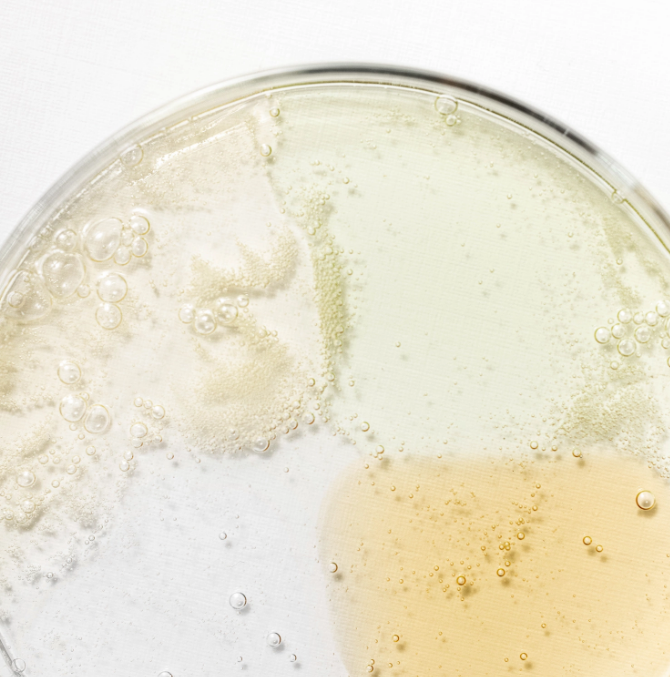
Beauty of Joseon Hanbang Serum Discovery Kit

$56.00 $19.00
$56.00 $19.00
$56.00 $19.00
$56.00 $19.00
$56.00 $19.00
$56.00 $19.00
$56.00 $19.00
$56.00 $19.00
$56.00 $19.00
$56.00 $19.00
$56.00 $19.00
$56.00 $19.00
$56.00 $19.00
$56.00 $19.00